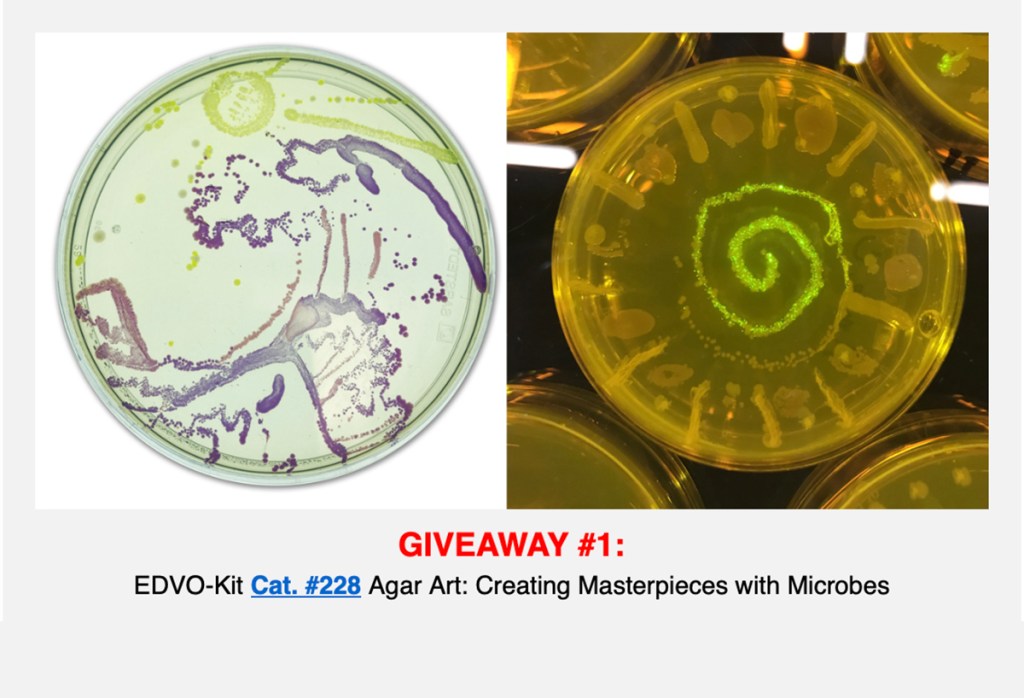

Happy Teacher Appreciation Week To All Our Favorite Educators!
Every year when the the first full week of May rolls around, we celebrate teachers and community educators. This special week encourages us to reflect on all of their contributions and the ways that we can give back. To celebrate, this year we’re hosting a giveaway of five fantastic prizes!
GIVEAWAY #1:
GIVEAWAY #2:

GIVEAWAY #3:

GIVEAWAY #4:

GIVEAWAY #5:

